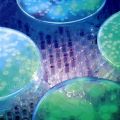
miniature

| <<< Mars 2008 >>> | ||||||
| L | M | M | J | V | S | D |
| 1 | 2 | |||||
| 3 | 4 | 5 | 6 | 7 | 8 | 9 |
| 10 | 11 | 12 | 13 | 14 | 15 | 16 |
| 17 | 18 | 19 | 20 | 21 | 22 | 23 |
| 24 | 25 | 26 | 27 | 28 | 29 | 30 |
| 31 | ||||||
| Sélectionner tout le mois | ||||||
Effondrement imminent de la barrière de Wilkins en Antarctique
Lundi 31 Mars 2008 à 00:41 | Vie et Terre
Les fullerènes la solution pour le stockage de l'hydrogène ?
Dimanche 30 Mars 2008 à 01:44 | Physique
Rétro 1926: Les merveilles de l'air: au service de la science (2/2)
Dimanche 30 Mars 2008 à 00:00 | Archéologie
ATV Jules Verne: la démonstration d'approche débute ce week-end
Samedi 29 Mars 2008 à 00:00 | Spatial
Charger sa voiture électrique sur n'importe quelle place de parking
Vendredi 28 Mars 2008 à 00:00 | Energie
Découverte d'un "cousin éloigné" des acides aminés dans l'espace
Vendredi 28 Mars 2008 à 00:00 | Astronomie
Transistors au graphène améliorés: bientôt des transistors de 10nm ?
Mercredi 26 Mars 2008 à 02:43 | Physique
Quels mystères cache la créature la plus forte du monde ?
Mercredi 26 Mars 2008 à 00:00 | Vie et Terre
Des photons "intriqués" pour améliorer notre vision des choses ?
Mercredi 26 Mars 2008 à 00:00 | Physique
Une source inattendue de radicaux libres dans l'atmosphère
Mardi 25 Mars 2008 à 00:00 | Vie et Terre
GRB 080319B: une prodigieuse explosion gamma visible à l'œil nu
Lundi 24 Mars 2008 à 00:00 | Astronomie
Un logiciel pour le contrôle acoustique de la qualité des fromages
Dimanche 23 Mars 2008 à 00:05 | Numérique
Des nanoparticules biphotoniques pour raffiner l'imagerie médicale
Dimanche 23 Mars 2008 à 00:00 | Physique
Rétro 1926: Les merveilles de l'air: au service de la science (1/2)
Dimanche 23 Mars 2008 à 00:00 | Archéologie
Des cyberlunettes qui enregistrent et répertorient notre entourage
Vendredi 21 Mars 2008 à 00:32 | Numérique
L'une des plus jeunes et brillantes galaxies de l'univers primordial
Jeudi 20 Mars 2008 à 00:00 | Astronomie
Un grand écran améliore fortement la productivité au bureau
Mardi 18 Mars 2008 à 00:33 | Numérique
Nouveautés chez les fabricants américains de microprocesseurs
Lundi 17 Mars 2008 à 01:10 | Numérique
Mars Express révèle une pseudo-tectonique des plaques sur Mars
Lundi 17 Mars 2008 à 00:51 | Spatial
Les coraux peuvent-ils croître malgré le manque d'espèces ?
Lundi 17 Mars 2008 à 00:00 | Vie et Terre
Robot lunaire, projet italien pour le concours Google Lunar X Prize
Dimanche 16 Mars 2008 à 01:45 | Spatial
Rétro 1926: Les merveilles de l'air: air bienfaisant ou destructeur
Dimanche 16 Mars 2008 à 00:00 | Archéologie
TNT HD: début du basculement vers le 16/9 pour France Télévisions
Samedi 15 Mars 2008 à 00:00 | Numérique
Nanoélectronique: observer en direct la compression de la lumière
Vendredi 14 Mars 2008 à 00:00 | Physique
ARTIS: la télé-échographie est-elle économiquement viable ?
Vendredi 14 Mars 2008 à 00:00 | Vie et Terre
Lithographie par extrêmes UV dans la fabrication de processeurs
Vendredi 14 Mars 2008 à 00:00 | Physique
Futures versions de l'ATV: transport habité à la mini station orbitale
Jeudi 13 Mars 2008 à 00:00 | Spatial
Aucun astronaute américain dans l'espace entre 2011 et 2015 ?
Mardi 11 Mars 2008 à 00:00 | Spatial
L'ATV en route vers la Station spatiale internationale (vidéo)
Dimanche 9 Mars 2008 à 09:00 | Spatial
Chasser les exoplanètes à l'aide de deux échiquiers et d'un triangle !
Dimanche 9 Mars 2008 à 00:00 | Astronomie
Rétro 1926: Les merveilles de l'air: de la Terre au zénith
Dimanche 9 Mars 2008 à 00:00 | Archéologie
Produire bientôt de la peau ou des vaisseaux sanguins ?
Vendredi 7 Mars 2008 à 00:00 | Vie et Terre
Récupération des clés de chiffrement dans les mémoires RAM
Vendredi 7 Mars 2008 à 00:00 | Physique
Ecosystème RFID: suivre toutes personnes et objets à la trace
Jeudi 6 Mars 2008 à 00:00 | Numérique
La sonde Phoenix surveillée par ses consoeurs pour son atterrissage
Mercredi 5 Mars 2008 à 00:59 | Spatial
Rinspeed sQuba: la voiture submersible de James Bond enfin réalité
Mardi 4 Mars 2008 à 00:00 | Transports
S'inspirer de la photosynthèse pour concevoir les cellules solaires
Dimanche 2 Mars 2008 à 00:00 | Energie
Aucun dossier répondant aux critères sélectionnés